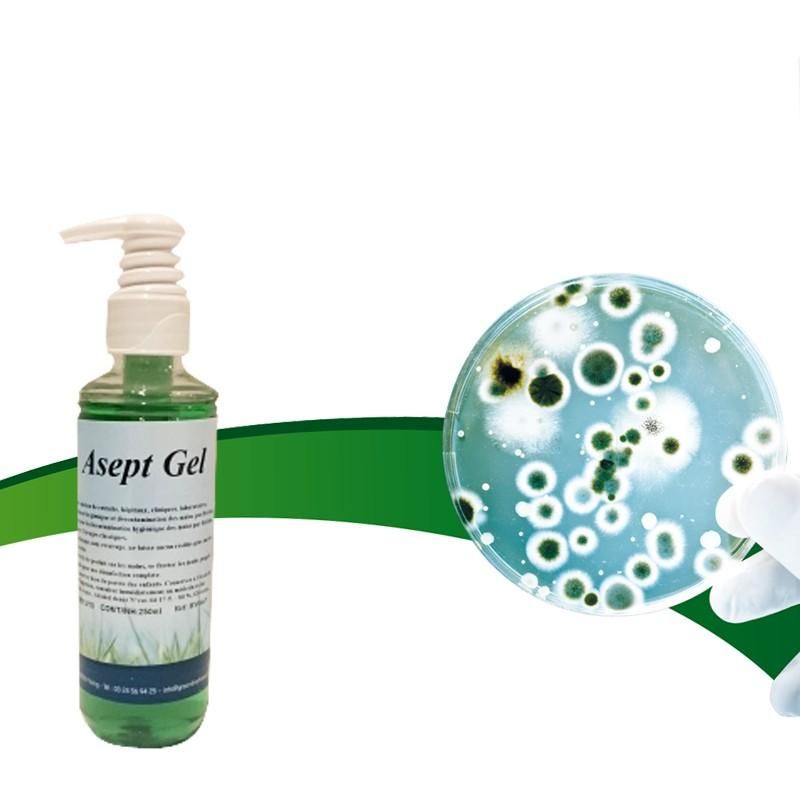

Asept Gel - Référence HYG-ASEGEL/250 - Gel hydroalcoolique mains sans rinçage - Parfum menthe ou pêche - 250ml
Obtenir un devis / prix
Prix et détails sur demande

Vendu
par GREEN LINE FRANCE
En savoir plus
Description
GEL HYDRO-ALCOOLIQUE POUR LES MAINS « SANS RINÇAGE »
Traitement hygiénique et décontamination des mains par friction.
Parfum : Menthe ou pêche
Caractéristiques :
Avantages :
Méthode d'utilisation :
Poids : 250 ml
Traitement hygiénique et décontamination des mains par friction.
Parfum : Menthe ou pêche
Caractéristiques :
- Gel hydro-alcoolique pour la décontamination hygiénique des mains par friction.
- Permet une sanitation immédiate des mains entre 2 lavages classiques.
Avantages :
- Prêt à l'emploi.
- Sans eau, sans rinçage, sans essuyage.
- Ne laisse aucun résidu gras sur les mains.
- Laisse un parfum frais et agréable (menthe ou pêche).
Méthode d'utilisation :
- Mettre une noisette de produit sur les mains.
- Se frotter les mains jusqu'à parfaite absorption.
- Bien insister sous les ongles pour une désinfection complète.
Poids : 250 ml
Produits similaires dans la catégorie qui peuvent vous intéresser

Prix sur demande
Vendu et fabriqué par : Mercurochrome / Laboratoires Juva Santé
GEL MAINS DÉSINFECTANT - PARFUM PAMPLEMOUSSE - Biocide - Le gel mains hydroalcoolique antibactérien* des Laboratoires Mercurochrome est idéal pour une hygiène des mains sans eau ni savon. - Il sèche rapidement et ne colle pas. - Caractéristiques : - Contenance : 75 ml - Antibactérien*
Voir le produit


3.15 € HT
Vendu par : ADEXGROUP
Le gel hydro - alcoolique Wyritol agit sur la désinfection des mains par friction. Caractéristiques principales : - À utiliser sans eau, sans rinçage, sans essuyage. - Activité : bactéricide, levuricide, virucide. - Formule : sans parfum, sans allergène, sans paraben. - Conditionnement :
Voir le produit


22.52 € HT
Vendu par : METRO
Vendeur certifié
DONNÉES TECHNIQUES - Aspect : Gel limpide incolore - Odeur : Alcool - pH : 6 +/ - 0.5 - Viscosité 20°C : 1500+/ - 200cPo - APPLICATION - Gel hydroalcoolique à usage externe, destinée à la désinfection rapide des mains. - S'utilise sur mains propres et sèches. Ne nécessite ni rinçage
Voir le produit


Prix sur demande
Vendu par : Gbknives
Vendeur certifié
Gel hydro - alcoolique Phagorub gel sps 100 ml. - Désinfection des mains - Actuellement indisponible. - Nous ne savons pas quand cet article sera de nouveau approvisionné ni s'il le sera. - Une référence de la désinfection des mains à l'hôpital - Descriptions Gel hydro - alcoolique Phago
Voir le produit

Prix sur demande
Vendu et fabriqué par : Mercurochrome / Laboratoires Juva Santé
Le Gel mains hydroalcoolique antibactérien* 250 ml des Laboratoires Mercurochrome est idéal pour une hygiène des mains sans eau ni savon. Il sèche rapidement et ne colle pas. Son format de 250 ml est idéal pour la maison ou dans les lieux de collectivité. - Caractéristiques principales : -
Voir le produit


À partir de43.73 € HT
Vendu par : AXESS INDUSTRIES
Vendeur certifié
Gel Hydroalcoolique 5l pour un nettoyage rapide des mains sans eau. Diminue rapidement les germes présentes sur les mains. Solution hydroalcoolique gélifiée qui ne colle pas aux mains et qui sèche rapidement, sans déshydrater ou desquamer l'épiderme. Contient de la glycérine ce qui évite l
Voir le produit


Prix sur demande
Vendu par : RLV FRANCE
Gel hydroalcoolique pour la décontamination des mains contenant un agent de protection pour la peau. Son aspect gélifié permet une utilisation rapide, pratique et efficace du produit. Caractéristiques : - Solution désinfectante, non moussante - Sans rinçage, ni essuyage - Sans résidus - �
Voir le produit


2.59 € HT
Vendu par : METRO
Vendeur certifié
DONNÉES TECHNIQUES - Aspect : Gel limpide incolore - Odeur : Alcool - pH : 6 +/ - 0.5 - Viscosité 20°C : 1500+/ - 200cPo - APPLICATION - Gel hydroalcoolique à usage externe, destinée à la désinfection rapide des mains. - S'utilise sur mains propres et sèches. Ne nécessite ni rinçage
Voir le produit


2.02 € HT
Vendu par : METRO
Vendeur certifié
DONNÉES TECHNIQUES - Aspect : Gel limpide incolore - Odeur : Alcool - pH : 6 +/ - 0.5 - Viscosité 20°C : 1500+/ - 200cPo - APPLICATION - Gel hydroalcoolique à usage externe, destinée à la désinfection rapide des mains. - S'utilise sur mains propres et sèches. Ne nécessite ni rinçage
Voir le produit


6.94 € HT
Vendu par : METRO
Vendeur certifié
DONNÉES TECHNIQUES - Aspect : Gel limpide incolore - Odeur : Alcool - pH : 6 +/ - 0.5 - Viscosité 20°C : 1500+/ - 200cPo - APPLICATION - Gel hydroalcoolique à usage externe, destinée à la désinfection rapide des mains. - S'utilise sur mains propres et sèches. Ne nécessite ni rinçage
Voir le produit
Obtenez des devis
pour plusieurs produits à la fois
1
Vous décrivez rapidement votre besoin de matériel
2
Nous sélectionnons les meilleurs fournisseurs pour votre projet
3
Vous recevez des premières propositions sous 48h
Vous recherchez un gel hydroalcoolique en : :

GREEN LINE FRANCE
France, DONCHERY, (08) Grand Est
GREEN LINE FRANCE est sur Hellopro depuis 6 ans
GREEN LINE France développe et fabrique des solutions pour le nettoyage, la maintenance, le bâtiment et les travaux public de façon éco-responsable. Notre usine de production fabrique des produits consommables depuis plus de 22 ans dans nos deux unités de production au service de ses revendeurs sur toute l'Europe et pour nos clients en direct sur la France et le Bénélux.
Notre savoir-faire, notre réactivité, nos connaissances techniques font de notre société un fabricant reconnu pour ses innovations, son respect de l'environnement et ses productions éco-responsable (Récupération des eaux de pluie, passage dans un osmoseur sur 3 filtres qui éliminent les nitrates, le chlore, les pesticides et résidus médicamenteux présent dans l'environnement).
ECO-CONCEPT ATTITUDE, SOLUTIONS DE NETTOYAGE GLOBALE ET ECO-RESPONSABLE. GREEN LINE France est implantée sur le réseau national pour commercialiser toute sa gamme de produits spécifiques (Nettoyants de surfaces, cuisine et agroalimentaire, sanitaires et surfaces, hygiène des mains, traitements des odeurs et insectes, savons d'ateliers, déverglaçant et déneigeant, dégraissants industriels, maintenance des bâtiments et peintures, traitements des graffitis, entretien des routes et parkings, entretien des véhicules, maintenance industrielle, solvant et dégoudronnants, traitement des espaces verts, colle et mastics.).
Notre savoir-faire, notre réactivité, nos connaissances techniques font de notre société un fabricant reconnu pour ses innovations, son respect de l'environnement et ses productions éco-responsable (Récupération des eaux de pluie, passage dans un osmoseur sur 3 filtres qui éliminent les nitrates, le chlore, les pesticides et résidus médicamenteux présent dans l'environnement).
ECO-CONCEPT ATTITUDE, SOLUTIONS DE NETTOYAGE GLOBALE ET ECO-RESPONSABLE. GREEN LINE France est implantée sur le réseau national pour commercialiser toute sa gamme de produits spécifiques (Nettoyants de surfaces, cuisine et agroalimentaire, sanitaires et surfaces, hygiène des mains, traitements des odeurs et insectes, savons d'ateliers, déverglaçant et déneigeant, dégraissants industriels, maintenance des bâtiments et peintures, traitements des graffitis, entretien des routes et parkings, entretien des véhicules, maintenance industrielle, solvant et dégoudronnants, traitement des espaces verts, colle et mastics.).
Notre ambition et de concevoir des produits le plus sécuritaires possibles pour l'utilisateur et l'environnement en travaillant avec des matières de nouvelles générations.
Notre capacité de fabrication nous permet de répondre rapidement et efficacement aux problèmes quotidien de nos clients ou futurs clients soit sur notre gamme existante, soit sur une fabrication sur mesure étant capable de conditionner du 100 millilitres au 1000 litres.
Nous formons selon les besoins du clients le personnel à l'utilisation de nos produits avec pour objectif une éco-attitude
Retrouvez nos conseils pour choisir
votre
gels hydroalcooliques


Le conseil de l'expert
Quel gel hydroalcoolique choisir ?
Découvrir